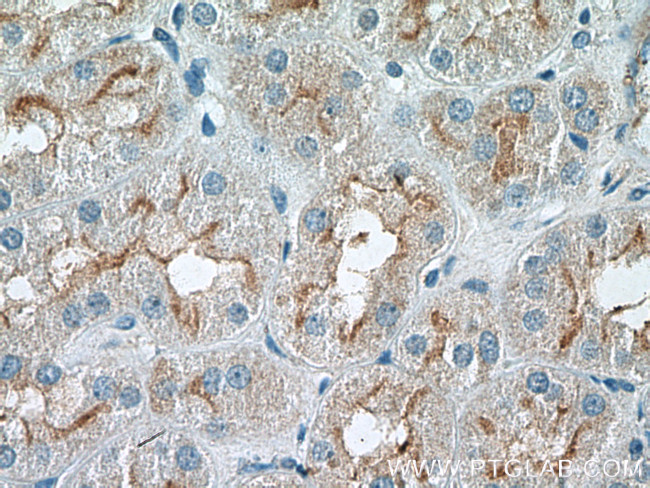
RNF144B/IBRDC2 Antibody in Immunohistochemistry (Paraffin) (IHC (P))

Search
Proteintech
RNF144B/IBRDC2 Polyclonal Antibody
{{$productOrderCtrl.translations['antibody.pdp.commerceCard.promotion.promotions']}}
{{$productOrderCtrl.translations['antibody.pdp.commerceCard.promotion.viewpromo']}}
{{$productOrderCtrl.translations['antibody.pdp.commerceCard.promotion.promocode']}}: {{promo.promoCode}} {{promo.promoTitle}} {{promo.promoDescription}}. {{$productOrderCtrl.translations['antibody.pdp.commerceCard.promotion.learnmore']}}
产品信息
26306-1-AP
种属反应
宿主/亚型
分类
类型
抗原
偶联物
形式
浓度
规格
纯化类型
保存液
内含物
保存条件
运输条件
产品详细信息
Immunogen sequence: VADCQTVCP VASSDPGQPV LVECPSCHLK FCSCCKDAWH AEVSCRDSQP IVLPTEHRAL FGTDAE (123-187 aa encoded by BC063311)
靶标信息
E3 ubiquitin-protein ligase which accepts ubiquitin from E2 ubiquitin-conjugating enzymes UBE2L3 and UBE2L6 in the form of a thioester and then directly transfers the ubiquitin to targeted substrates such as LCMT2, thereby promoting their degradation. Induces apoptosis via a p53/TP53-dependent but caspase-independent mechanism. However, its overexpression also produces a decrease of the ubiquitin-dependent stability of BAX, a pro-apoptotic protein, ultimately leading to protection of cell death; But, it is not an anti-apoptotic protein per se.
仅用于科研。不用于诊断过程。未经明确授权不得转售。
篇参考文献 (0)
生物信息学
蛋白别名: E3 ubiquitin-protein ligase RNF144B; IBR domain containing 2; IBR domain-containing protein 2; p53-inducible RING finger protein; RING finger protein 144B; unnamed protein product
基因别名: bA528A10.3; IBRDC2; P53RFP; PIR2; RNF144B
UniProt ID: (Human) Q8N3R7
Entrez Gene ID: (Human) 255488